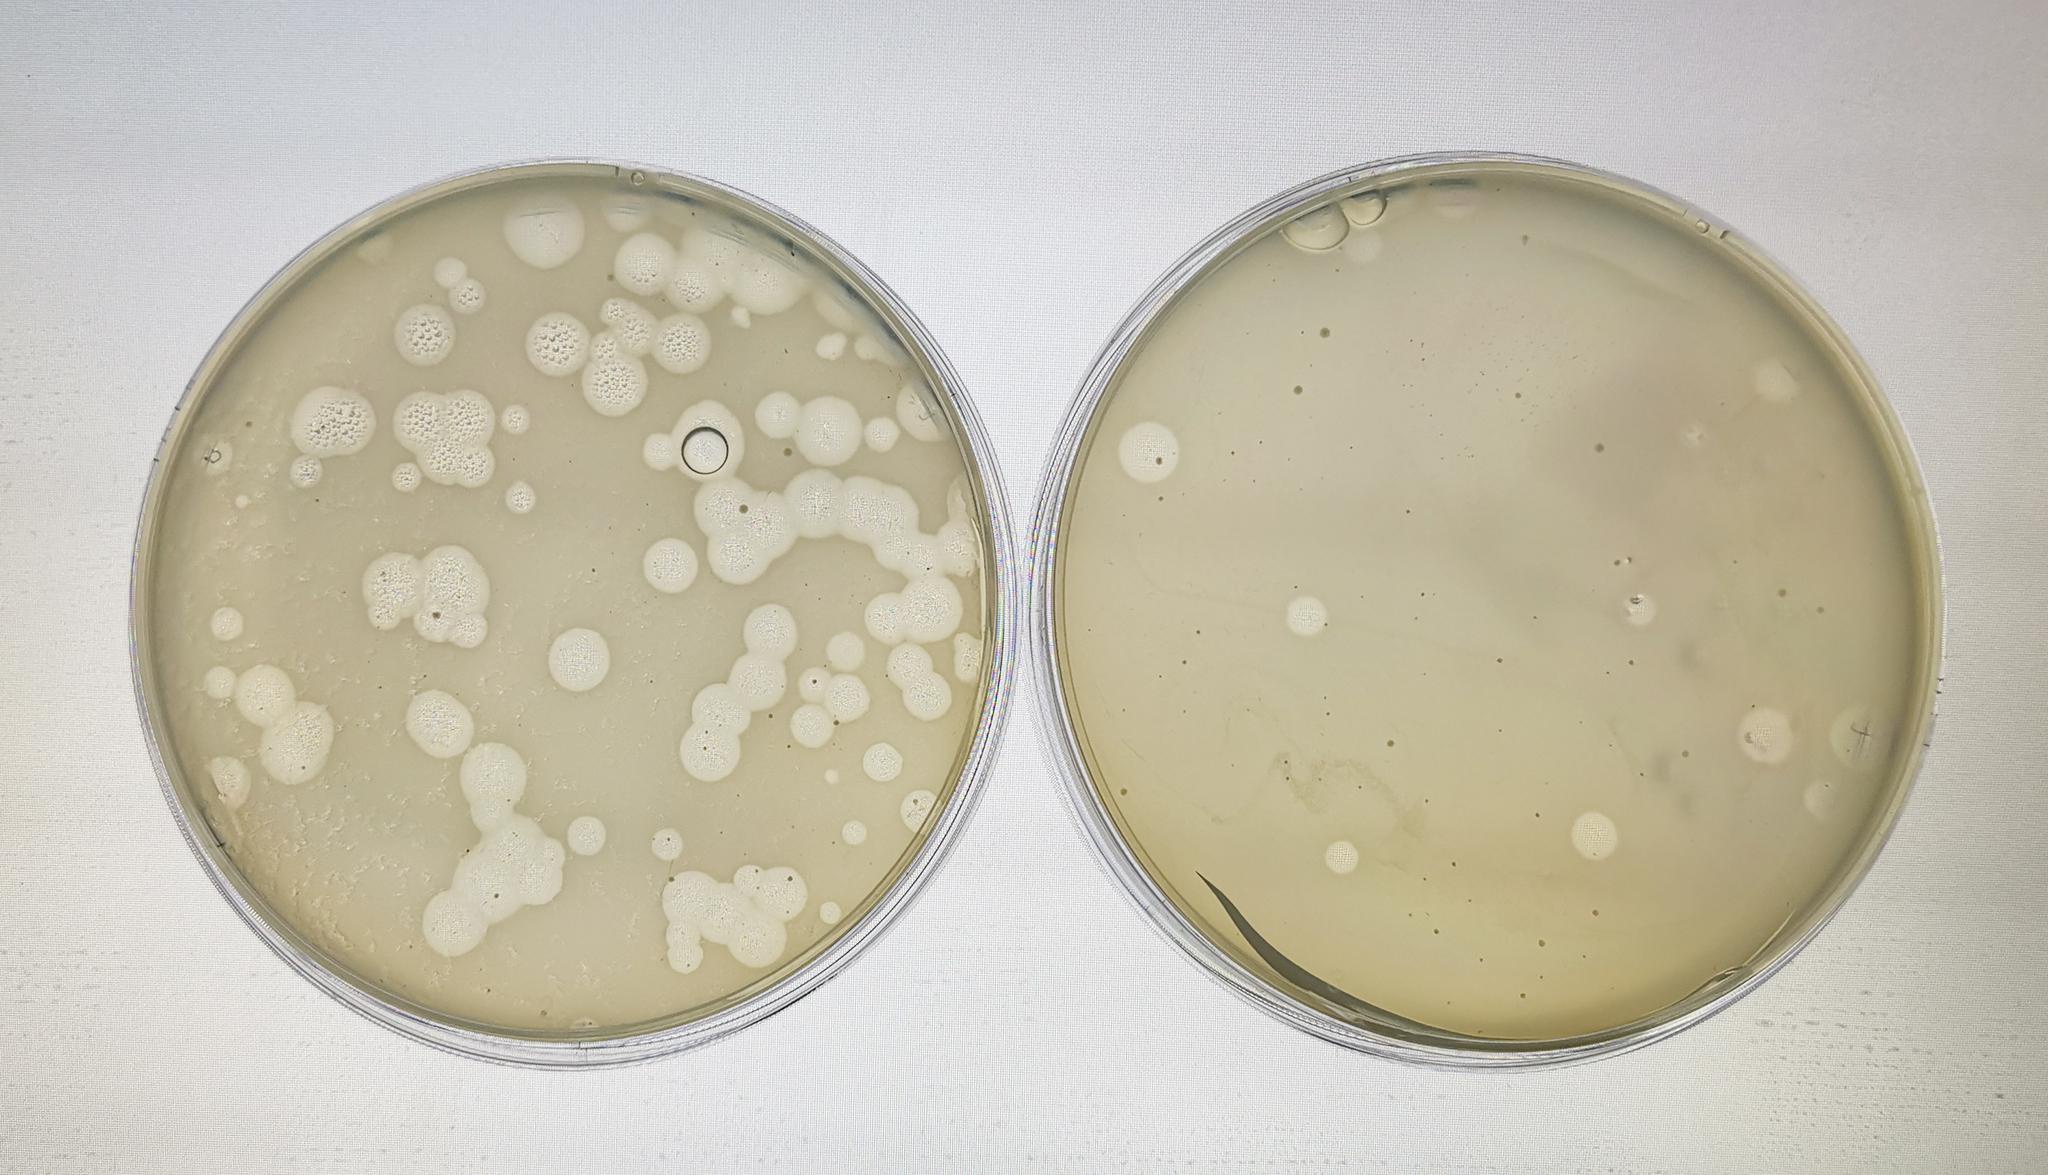

其實追根溯源,人類本能需求的開發和升華一直都是社會發展的原動力。就拿我們最最熟悉的洗衣機來說,隨著時間的推移,洗衣機產品的進化一直都和人們的需求同步著。從最初簡單的清洗、甩干,到追求潔凈、健康,從倡導綠色、環保,到如今流行的洗烘、智控,在各類人群不同的消費需求下,洗衣機細分出了更多的功能類型,而這些統統讓洗衣機本身被賦予了更多意義。

當前,新冠肺炎疫情正在肆虐全球,越來越多的消費者開始關注健康家電領域,而在這其中,帶有除菌功能的洗衣機產品尤為受到人們的喜愛。
目前在市場上,多數洗衣機產品的除菌模式都采用高溫洗滌,高溫雖然對一些病菌可以起到滅活的效果,但是,畢竟不是所有衣物都適合高溫洗,一些特殊的面料(如絲綢、羊絨、毛呢等)另需特別呵護或單獨清洗;另外,衣物若經長期反復的高溫洗滌,還會有縮水、變形、褪色的問題出現,在能耗方面長久下來也是一筆不小的開支。
 全新松下L系高級護理洗衣機
全新松下L系高級護理洗衣機
針對上述這樣的衣物洗護痛點,深耕洗衣機行業多年的松下,通過研發團隊的不懈努力,特別研出了獨特的解決方案。以全新的“NanoeX納諾怡技術”和“光動銀除菌技術”為突破,不僅將新品松下洗衣機的功能全面提升,更集合了除味、除菌、護色、防變形于一體,高效環保又兼顧人性化,大大滿足廣大消費者的高端衣物洗護需求。
【1+1>2,讓衣物健康洗護成為現實】
1、NanoeX納諾怡技術
作為松下目前最具代表性的前沿專利技術之一,“NanoeX納諾怡技術”可謂成就非凡。該項技術在常溫狀態下,可通過施加高電壓分離空氣中的水分子,進而產生直徑約為1nm-100nm的納米水離子,僅需少量噴淋就能滲透到衣物纖維深處,不僅能夠迅速剝離附著在衣物上的細菌和異味,殺死有害微生物,同時還能呵護纖維原有的彈性,使衣物順滑無褶皺,自然蓬松,舒適柔軟。
此外,由于納米水離子本屬于弱酸性,且具有親和蛋白質的特性,因此對羊毛、真絲等動物蛋白纖維的衣物更具呵護效果,洗出的羊毛蓬松柔軟、絲綢光彩不減,效果顯著。

用戶在使用帶有“NanoeX納諾怡技術”的松下洗衣機時,只需選擇“NanoeX護衣”程序,即可讓衣物享受全程都在40℃以下常溫洗滌的高端護理,無需洗滌劑,大大避免了對衣物的刺激,而這種只需8-15分鐘就能搞定的高效便捷洗護方式,也十分符合現代人快節奏的生活習慣。值得一提的是,在整個洗護過程中,松下洗衣機的機門可以隨時開啟,添衣取衣非常方便,細節設計十分人性化。
2、光動銀除菌技術
作為松下的另一項特色技術,“光動銀除菌技術”的優勢不可小覷。該項技術是在銀離子除菌的基礎上,通過在洗衣機筒內特設的近紫外線光照射作用下,促使銀離子(Ag+)和水分子(H2O)發生反應,所產生的羥基自由基(?OH)與銀離子共同發揮雙重除菌威力。

在洗滌衣物時,用戶只需在松下洗衣機上選擇合適的洗滌程序,同時再選擇使用光動銀除菌功能,無需高溫加熱,沒有增加額外的耗電,僅需靠常溫甚至冷水洗滌即可完成對衣物的清潔和除菌,且除菌率能達到99.9%以上。該項技術可使貼身衣物洗后保持不變形、穿著更舒適,可讓彩色衣物鮮艷不褪色、時刻保持清新。另外,松下的光動銀除菌技術還能在洗滌過程中,給衣物表面及洗衣機內筒表面形成保護膜,借此帶來長久的抑菌效果。
【四重考驗又如何,松下洗衣機輕松破局】
在對松下“NanoeX納諾怡技術”和“光動銀除菌技術”進行了深層解讀后,相信大家對這兩項技術都有了初步的了解。但是常言道“實踐出真知”,究竟這兩項技術的“實戰”效果如何,下面我們就通過全方位的四項測試,為大家直觀展示。
一、除菌測試
人們日常出行的時候,衣物不可避免的會暴露在外面,由于外界環境復雜,衣物上被病毒和細菌附著的可能性還是很高的。如果使用酒精對衣物進行消毒,若遇明火或靜電會產生危險,而84消毒液的腐蝕性又很強,很容易傷手或腐蝕衣物。
如此說來,松下的“NanoeX納諾怡技術”和“光動銀除菌技術”恰好可以針對這類問題完美解決。只是,廣告宣傳雖然夸得好,但究竟這兩項技術的真實除菌效果如何?我們速來圍觀中國家用電器研究院專業實驗室的實測情況吧!
1、NanoeX除菌檢測
檢測菌種:
※噬菌體病毒——一種大量存在于環境和人體內的細菌病毒,它不侵染人類,只是寄生在細菌體內,所以有些噬菌體可幫助人們消滅某些有害細菌,當然,對于人類有益的細菌也可能會遭到噬菌體的侵害。
※白色念珠菌——一種真菌,通常會存在于正常人的口腔、上呼吸道、腸道及陰道內。一般這種菌在正常機體中數量較少,不會引起疾病,但若當機體免疫功能降低時,它就會趁虛而入,引起口角炎、陰道炎、鵝口瘡等疾病。
操作步驟:
配置濃度為105cFu/ml的實驗用菌液,將菌液均勻滴在試驗樣塊上,待樣塊干后將其固定在負載布的正中間,按程序要求稱取負載1kg,將負載布按照標準放入洗衣機中,執行“NanoeX除菌”程序。與此同時,將對照組放在帶蓋無菌的培養皿中,在室溫下靜置相同時間。

洗滌完后,將試驗樣塊放入無菌采樣袋中,通過震蕩獲取洗后試驗樣塊上的細菌,并進行一定倍數的稀釋以便計數;在培養皿中加入培養基,然后放入恒溫箱進行培養(37℃,24小時),最后分別對試驗組和對照組進行計數,計算除菌率。
噬菌體病毒對比
噬菌體病毒對比
 白色念珠菌對比
白色念珠菌對比
結論:依據相關標準,經檢測,在松下“NanoeX納諾怡技術”的作用下,噬菌體病毒的除病毒率大于99.99%,白色念珠菌的除菌率在98.78%,除菌效果肉眼直觀可見,非常優秀。
2、光動銀除菌檢測
檢測菌種:
※白色念珠菌——(詳情同上)
操作步驟:
配置濃度為109cFu/ml的實驗用菌液,將菌液均勻滴在試驗樣塊上,待樣塊干后將其固定在負載布的正中間,稱取負載,負載量為測試程序額定負載量的30%,也就是3kg,將負載布按照標準放入洗衣機中,試驗組執行“棉織物洗滌程序+光動銀除菌功能”,而對照組執行“棉織物洗滌程序”。

洗滌完后,將試驗樣塊放入無菌采樣袋中,通過震蕩獲取洗后試驗樣塊上的細菌,并進行一定倍數的稀釋以便計數;在培養皿中加入培養基,然后放入恒溫箱進行培養(37℃,24小時),最后分別對試驗組和對照組進行計數,計算除菌率。
 白色念珠菌對比
白色念珠菌對比
結論:依據相關標準,經檢測,在松下“光動銀除菌技術”的作用下,白色念珠菌的除菌率在98.31%,除菌效果肉眼直觀可見,成績斐然。
二、除味測試
衣物上沾染了異味該怎樣去除?風吹拍打基本沒啥用,噴香水只是治標不治本,用帶有香精的洗滌產品一通猛操作倒是有點效果,但是織物上殘留的化學試劑要廢多少水才能徹底清干凈?對此,松下洗衣機的“NanoeX納諾怡技術”正好派上用場。
我們分別將兩件純棉T恤衫用被稀釋過的84消毒液進行浸泡,然后陰干。

待兩件T恤衫徹底干后,其中一件不做任何處理,直接放入提前準備好的密封箱內備用;而另一件則放入松下洗衣機內,選擇“NanoeX護理”程序進行護理,待全部流程結束后再將衣服放入另一個密封箱內。


隨機邀請10名消費者分別對兩個密封箱進行嗅聞,對比兩件衣物的除味效果,最終進行投票和評分。

最終的評分結果如下:

與此同時,我們還特別邀請了一名專業的活體氣味品鑒師——“小恐龍”來參與到測試環節。作為嗅覺非常靈敏的喵咪本咪,在面對兩件氣味截然不同的衣服時,小恐龍顯然對第一件帶有濃濃消毒液味道的衣服非常抗拒,而對第二件經過松下NanoeX納諾怡技術護理過的衣服,小恐龍的喜愛之情簡直要溢出屏幕啦有木有!

結論:通過實際的對比嗅聞發現,經由松下NanoeX納諾怡技術洗滌后的衣物除味效果顯著,哪怕是濃烈的消毒水味道,也可輕松去除。
三、護色+變形測試
在前文中我們提到過,鮮艷衣物若經長期反復的高溫洗滌,會有縮水、變形、褪色等問題出現,而松下的“光動銀除菌技術”功能,又恰好針對這一洗護痛點進行了完美解決。究竟它的實際效果如何,我們拭目以待。
在本項測試中,我們將兩件大紅色的純棉T恤衫,分別使用“90℃以上的高溫除菌洗”和松下的“光動銀除菌洗”,在連續洗滌3遍后,取出衣服進行陰干。

首先,對兩件衣服分別測量和對比洗滌前后的色差值,數值越大,表示衣服褪色越嚴重;其次,分別對兩件衣服進行測量(平鋪后測量從衣袖腋下部位到底邊衣角的距離),計算得出衣物扭曲度并進行對比,數值越大,表示衣物變形或縮水的越厲害。


最后得出的數據如下:

結論:在護色測試中,經由專業測量儀器檢測和T檢驗,采用光動銀除菌洗后的衣物色差數值與最初的顏色差異較小,可見采用光動銀除菌技術的冷水洗滌對衣物護色有明顯效果。而在變形測試中,同樣是光動銀除菌洗后的衣物扭曲度更小。這也印證了松下光動銀除菌技術的確能使貼身衣物洗后保持不變形、穿著更舒適,可讓彩色衣物鮮艷不褪色、時刻保持清新的真實效果。
【寫在最后】
常言道“魚和熊掌不可兼得”,但是在科技發展日益迅猛的今天,松下卻改寫了這一固有定式,通過悉心鉆研“NanoeX納諾怡技術”和“光動銀除菌技術”,讓衣物的洗滌、除菌、除味、護理等多方面多效合一,以這種小小的改變,不斷推動家電科技的發展,更讓那些追求高品質生活的人們享受到全面的呵護。


